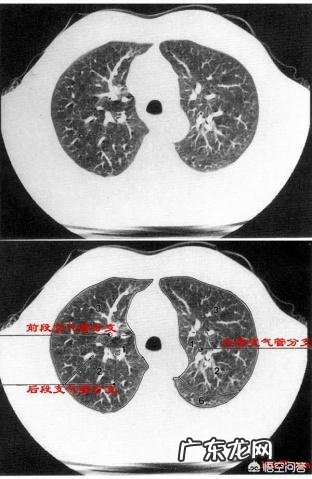

近日,在网上看到这样的问题,说中国演技最好的男演员前十名都有谁?这个问题很有意思,当然这是仁者见仁智者见智的问题 。今天,张大夫想说的是,人体的器官组织那么多,重要性排名前五的都有谁?不知道大家有什么样的回答?现在,张大夫就说一说自己心目中的脏器重要性排名(脏器功能非常强大,绝不仅仅是下面我提到的功能) 。

文章插图
需要声明一下,张大夫认为人体所有的器官都是非常重要的,小到头发,大到心脏、大脑,对人体都有着不可或缺的作用 。任何一个器官出了问题,都可能会影响机体的正常机能,甚至会致死致残 。
第一、心脏心脏负责“泵血”,把动脉血输送到全身各个器官和组织的同时,也把氧气和其他营养物质带到器官和组织;静脉血回流入心脏 。因此,心脏在维持其他组织器官的正常机能和代谢方面,发挥着重要价值 。

文章插图
第二、大脑大脑支配和管理着人的一切生命活动,包括运动、情感、逻辑思维、学习等等,可以说人与动物最主要的区别,就是大脑 。

文章插图
第三、肺大家都了解了,负责着人类机体的气体交换 。将新鲜的氧气带入机体内,同时将人体产生的二氧化碳排出体外 。如果肺功能衰竭,人体将面临巨大挑战 。
文章插图
第四、肝脏是重要的代谢器官和解毒器官,不仅负责着脂肪、蛋白质、糖类等物质的代谢和转化,还负责大部分毒素和药物的代谢和分解 。因此,肝脏也是人体非常重要器官 。

文章插图
第五、肾脏肾脏最主要的功能就是排泄体内产生的各种代谢废物,同时,还维持机体电解质和酸碱的平衡,因此,肾功能衰竭时,机体的各种废物不能排出,将严重影响机体的正常运行 。

文章插图
当然,这种排名不分先后 。除此之外,骨骼重要吗?皮肤重要吗?胃重要吗?胰腺重要吗?耳朵重要吗?眼睛重要吗?其实所有的器官都很重要,而且组织之间是相互有联系的,每一种器官都缺一不可 。

文章插图
首先要说明一点,人体器官都非常重要,可以说它们各司其职,对人体来说都是重要的组成!我认为重要性排名前五的是以下几个
第一名,大脑!大脑是人体的"司令员",是生命中枢所在!目前许多脏器都已经成功的实现了移植,可以换肾,换肺,换心脏,但是换脑还是十分困难的!这里不仅仅是技术上的问题,同时还存在许许多多的伦理问题 。比如换脑后记性是否可以移植?一个人的"精神"是否会一直"传承" 。想想多可怕!

文章插图
第二名,心脏!心脏是生命的源泉!我还记得大学的时候解剖学教授讲过一句话"生命不息,心跳不止!"心脏每时每刻都在给我们人体各个角落提供血液,提供营养物质 。可见心脏之重要性!

文章插图
第三名,皮肤!我把皮肤这个全身最大的"器官"排在第三位是因为我觉得它是人体最重要的"守卫者"!还记得轮科的时候烧伤科给我的印象最深刻 。只有去了烧伤科的朋友才知道皮肤有多么重要 。皮肤可以保护我们日常生活中免受各种侵略,比如细菌、病毒!失去皮肤以后,我们人体就像城墙失守!敌人随时可以杀到城里,直接要命!
- 中山24岁小伙遇车祸脑死亡,家人捐其器官救助他人, 你怎么看?
- 法律重要性的名言警句 关于法律的经典句子
- 西医和中医对人体的认识,哪一个更本质?
- 长期使用电脑,电脑辐射对人体危害有哪些?怎样减少辐射?
- 夏季高温天气对人体有什么影响?怎样做好夏季养生?
- 甲醛到底是什么?有人体哪些危害?
- 秋葵中黏黏的液体是什么?对人体有什么好处?
- 陨石有辐射吗,对人体如何?
- 旋风网络加速器官网 安卓旋风网络加速器
- 海参是百补之首,海参中的哪些成分具有滋补,对人体有用?
特别声明:本站内容均来自网友提供或互联网,仅供参考,请勿用于商业和其他非法用途。如果侵犯了您的权益请与我们联系,我们将在24小时内删除。
